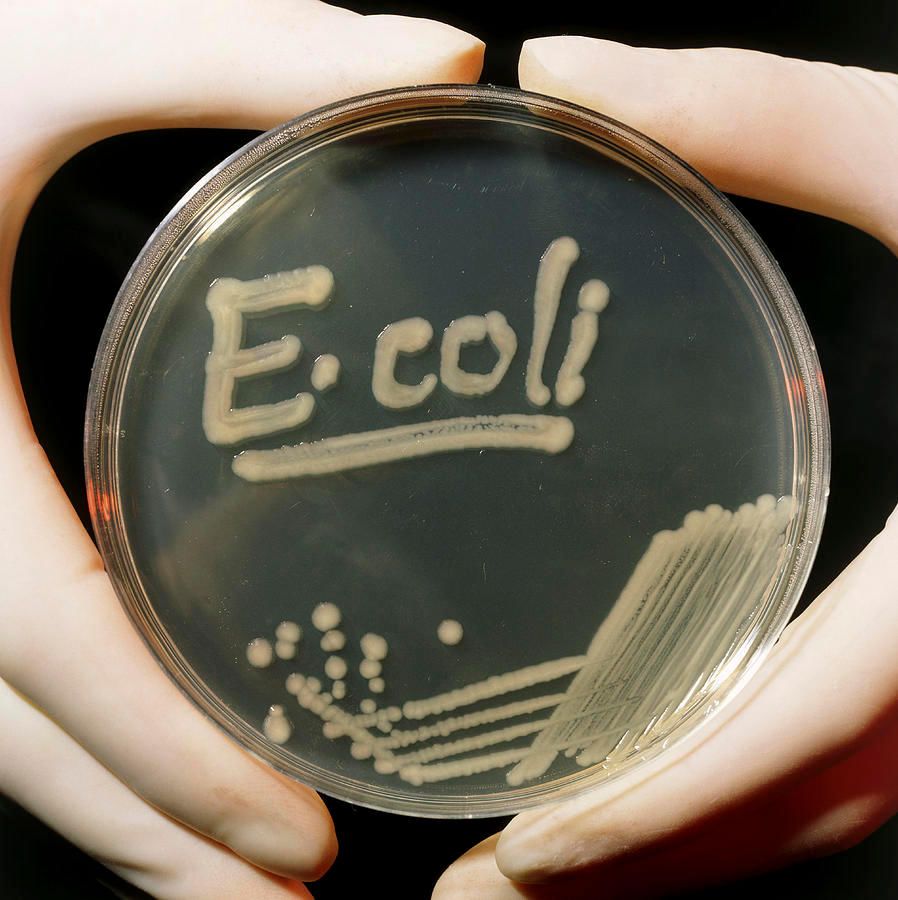

The AI-generated cat pictures thread
**** chipotle. I've been boycotting them since they started charging extra for quesaritos.
And they got karma'd
40 E. coli cases in Northwest linked to Chipotle outbreak
And they got karma'd
40 E. coli cases in Northwest linked to Chipotle outbreak
Nov 10 (Reuters) - Chipotle Mexican Grill Inc said it would reopen all 43 restaurants in Seattle and Portland after health officials found no evidence of E. coli bacteria at those outlets.
The company closed the restaurants on Oct. 31 after a reported outbreak of E. coli, which caused food poisoning among some people who had eaten at eight of its restaurants.
SEE ALSO: No source found for E. coli; Chipotle could reopen midweek
Health officials have concluded that there is no ongoing risk from the incident, Chipotle said on Tuesday.
Washington state epidemiologist Dr. Scott Lindquist says all the tests of food from Chipotle stores in Washington and Oregon came back negative for E. coli. Chipotle did its own testing, and those results came back negative as well.
Last edited by good2go; Nov 10, 2015 at 01:49 PM.
Joined: Oct 2011
Posts: 5,731
Total Cats: 830
From: Detroit (the part with no rules or laws)
Joined: Sep 2005
Posts: 34,415
Total Cats: 7,531
From: Chicago. (The less-murder part.)
But ...
Nov 10 (Reuters) - Chipotle Mexican Grill Inc said it would reopen all 43 restaurants in Seattle and Portland after health officials found no evidence of E. coli bacteria at those outlets.
The company closed the restaurants on Oct. 31 after a reported outbreak of E. coli, which caused food poisoning among some people who had eaten at eight of its restaurants.
SEE ALSO: No source found for E. coli; Chipotle could reopen midweek
Health officials have concluded that there is no ongoing risk from the incident, Chipotle said on Tuesday.
Washington state epidemiologist Dr. Scott Lindquist says all the tests of food from Chipotle stores in Washington and Oregon came back negative for E. coli. Chipotle did its own testing, and those results came back negative as well.
Nov 10 (Reuters) - Chipotle Mexican Grill Inc said it would reopen all 43 restaurants in Seattle and Portland after health officials found no evidence of E. coli bacteria at those outlets.
The company closed the restaurants on Oct. 31 after a reported outbreak of E. coli, which caused food poisoning among some people who had eaten at eight of its restaurants.
SEE ALSO: No source found for E. coli; Chipotle could reopen midweek
Health officials have concluded that there is no ongoing risk from the incident, Chipotle said on Tuesday.
Washington state epidemiologist Dr. Scott Lindquist says all the tests of food from Chipotle stores in Washington and Oregon came back negative for E. coli. Chipotle did its own testing, and those results came back negative as well.

Joined: Sep 2005
Posts: 34,415
Total Cats: 7,531
From: Chicago. (The less-murder part.)
Unrelated: This happens to me at least once a day.

Joined: Jun 2005
Posts: 19,338
Total Cats: 574
From: Fake Virginia
The markup goes to cover the cost of people like me who get in line behind greedy gluttons who want cheesy tortillas appended to their burro and cause the production line to slow down and then unnecessarily speed up faster than normal, thus causing errors or lack of "letting the juice drain from the spoon" when they make my bowl resulting in this:

Which then results in me writing to them about the problem.
Which results in this:

So you see, $3.50 is a very small contribution to cover the cost of my free burritos.
Which then results in me writing to them about the problem.
Which results in this:
So you see, $3.50 is a very small contribution to cover the cost of my free burritos.
Joined: Sep 2005
Posts: 34,415
Total Cats: 7,531
From: Chicago. (The less-murder part.)
What mesmerized me about the in-car video was how the driver always seemed to know where his front wheels were pointing, despite what appeared to be a lot of flailing at the wheel. Whenever he exited a curve, no matter where his hands were on the wheel, he managed to snap it back to straight ahead - no shuffling, no letting it slide through his fingers, just bam! straight ahead. It's humbling to see how much improvement I have to make in my own driving. Also: I'm guessing that these old non-power racks had a very slow ratio. Dude looks like he's captaining a (very fast) yacht.
Also, what looked like pure chaos from inside the car sure produced a fine ballet when you saw how the car danced through the curves from outside shots. Very impressive, and yes, that ***-engined **** slot car appeared to be doing its best to kill its driver.
Also, what looked like pure chaos from inside the car sure produced a fine ballet when you saw how the car danced through the curves from outside shots. Very impressive, and yes, that ***-engined **** slot car appeared to be doing its best to kill its driver.





















